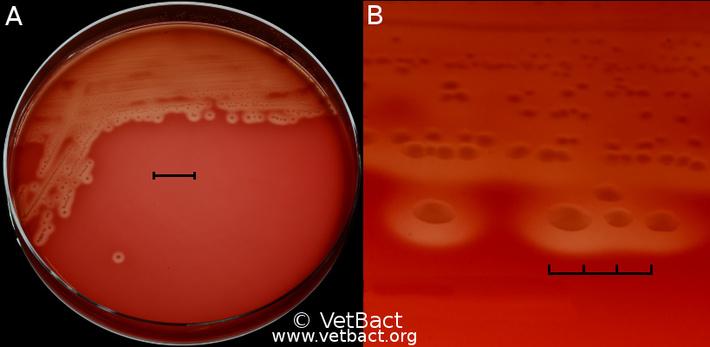

21 november 2014, 18:13
Virus och kvarka
Hej bloggen!
Long time no see, men så blir det i tyvärr i tentatider. Nu har jag skrivt två på raken och båda kändes okej, så nu är det bara att hålla tummarna! Har även hunnit med en resa ner till Lund och där prioriterades inte bloggen även om det var tänkt att jag skulle skriva ett inlägg förra helgen. Nåväl, förra veckan var jag på Universitets Djursjukhuset för en föreläsningskväll med temat "Hjälp, min häst har feber!". Föreläsningen var riktad till hästägare men vi var många veterinärettor som var där för att få lite inspiration till histologiplugget.
Vi började prata om vaccinering mot hästinfluensa som är ett globalt problem, men där några länder är undantagna. Till exempel så är Australien helt fritt från hästinfluensa. De hade ett utbrott 2007 men efter en massiv insats utrotades sjukdomen. I Sverige däremot insjuknar några hästar varje år, förra året var det bara 6 medan det 2007 var hela 82 stycken. Vaccinerade hästar får oftast inga eller lätta symptom som går över snabbt. Dessutom sprids en mindre mängd virus av de vaccinerade. Symptomen hos ovaccinerade hästar är betydligt värre och de insjuknar snabbt. Bland annat så får de
hög feber
en djup torr hosta
näsflöde (seröst som övergår till muköst)
nedsatt foderlust
ömma muskler
Svullna ben och skap
För att diagnostisera hästinfluensa ser man till de kliniska symptomen som jag skrivit om ovan och man tar ett nässvabbsprov (helst så tidigt som möjligt). På nässvabben kör man sedan en så kallad PCR som kortfattat är en sätt att undersöka virusets arvsmassa (RNA). Vid misstanke om hästinfluensa är det viktigt att isolera den sjuka hästen för att hindra spridning av viruset. Utöver det gäller det att hålla koll på hästen och tempa dagligen för att se om febern stiger eller sjunker. Behandlingen sI Sverige är typ B vanligast och den är även lättare att påvisa. Rhinitvirus sprids via luften, direktkontakt samt saliv och urin i upp till 4 veckor efter om sätts in är i första hand understödjande då de flesta hästar klarar av att läka ut influensan av sig själva. Vid en sekundär baktrerieinfektion kan dock antibiotika behövas.
När man ska sätta igång hästen ska detta göras försiktigt. En riktlinje att gå efter är 1 veckas vila per feberdag. Det vill säga har hästen varit sjuk i 4 dagar ska den vila i 4 veckor. Kom även ihåg att hästinfluensa är en anmälningspliktig sjukdom!
Andra gånger hästen kan få feber är om den smittas med Rhinitvirus A & B (kallades tidigare Rhinovirus) som är relativt vanliga förkylningsvirus. Typ B är den som är vanligast i Sverige och är även lättast att påvisa. Rhinitvirus ger ganska milda symptom; näsflöde, feber, förstorade lymfknutor och eventuell hosta. Behandlingen är i princip den samma som för hästinfluensa, då de båda ju är virussjukdomar.
För att diagnostisera Rhinitvirus kan man göra så kallade parprover där man analyserar de stigande antikroppsnivåerna i blodet med 10-14 dagars mellanrum. Det första provet tas när hästen är frisk eller precis i början av infektionen och sätter ett standardvärde, hästen har då få antikroppar mot Rhinitviruset. När de 10-14 dagarna har gått och man tar det andra provet mäts antalet antikroppar igen. Är värdet markant högre tyder det på att hästen har infektionen i kroppen och vill bekämpa det genom att antikroppar av rätt sort bildas. Man har alltså påvisat viruset.
Vidare togs arteritvirus och olika herpesvirus upp. Jag kommer eventuellt att att skriva mer om dessa i framtiden men just nu är jag alldeles för insnöad på kvarka för att tänka på något annat, hehe.
Bakterieodling av Streptococcus equi equi
Kvarka är tillskillnad från de andra sjukdomarna en bakteriesjukdom och har ett ökänt rykte, med all rätt. Det är en mycket smittsam luftvägssjukdom som orsakas av Sterptococcus equi subspecies equi. Jag har, tack och lov, aldrig stått i ett stall med kvarkautbrott men som hästägare vet man att det tar lång tid innan allt återgår till det normala. Däremot, har jag inte förrän nu verkligen börjar förstå omfattningen av ett kvarkautbrott. Men vi börjar från början.
De klassiska kliniska symptomen för kvarka som visas hos hästar utan antikroppar är:
Feber
Nedsatt aptit
Nedsatt allmäntillstånd
Tjockt näsflöde
Förstorade lymfknutor i form av bölder i huvud och halsregionen
Hos medelådershästar som har antikroppar är symptomen mildare och kan ibland misstas för virusinfektioner.
Hos ungefär 20% av hästarna med kvarka uppkommer komplikationer. Tillexempel kan kvarkan sprida sig (metastasera) och infektionen kommer då till andra delar i kroppen och bildar bölder. Även lunginflammation och lungsäcksinflammation är allvarliga följdsjukdomar som kan uppkomma. Om däremot inga komplikationer har stötts på är prognosen oftast god.
Problemet med kvarka är att bli av med det och här är så kallade tysta smittbärare den största boven i dramat. Det vill säga hästar som har genomgått sjukdomen, är symptomfria men fortfarande sprider bakterien till omgivningen. Svenska Travsportens Centralförbund, STC, har i sitt smittskyddsreglemente skrivit: "Stallet skall hållas isolerat intill dess att 20 dygn har förflutit från det att ingen häst längre visar symptom som näsflytning eller feber." Sveriges Veterinärmedicinska Anstalt har en något längre rekommendation, 4-6 veckor för att minska spridningen av bakterier.
Under veterinärkongressen presenterades en studie* om tysta smittbärare och för den gemene hästägaren tror jag att följande siffor är skrämmande (det var det för mig i alla fall!):
92% av de undersökta hästarna var ännu smittbärare efter "sedvanlig treveckors isolering" efterkvarka
58% av hästarna var smittbärare efter 6 veckors isolering
33% tysta smittbärare kunde påvisas i två besättningar 7 månader respektive 2 år efter att det akuta utbrottet var över, medan två besättningar blev fria från smittan efter 6 respektive 7 månader.
Att tävlingsplatser och andra hästtäta evenemang innebär en stor smittorisk (för många typer av sjukdomar) är givet. Men även varje gång en ny häst flyttar in i stallet bör den ses som en potentiell smittospridare. För som sagt, även om just den hästen verkar frisk kan man inte med säkerhet säga att den inte bär med sig sjukdomar. Det är då viktigt att vara extra nogrann med hygienen vid sådana tillfällen, till exempel inte dela på vattenhinkar och krubbor, och inte hälsa på alla gulliga hästar :)Nej, nu ska jag ta en välförtjänt helg på riktigt. Och imorgon är det Öppet Hus på UDS så förhoppningsvis har jag något spännande att berätta då.
Ha det fint /Annie :)
*Gittan Gröndahl: Kvarka - bakgrund, smittskydd, isoleringsrutiner och pågående forskning
ANNONS:
ANNONS: